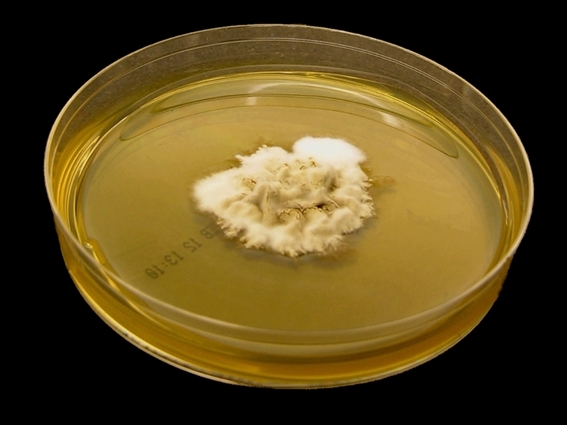

Изображения Epidermophyton floccosum

Раздел: Природная галерея